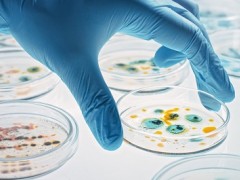

- 地黄双参鹿茸丸是真的吗 盘点地黄双参鹿茸丸的功效
0评论2025-10-05
- 治疗脚气的特效药 脚气最怕三种药品
0评论2025-10-05

- 银角惯爱是什么 银角惯爱有什么作用
0评论2025-10-05

- 他达拉非片哪个品牌的好 介绍4个他达拉非片牌子
0评论2025-10-05

- 男性十大助勃药 哪些药物助勃效果好
0评论2025-10-05

- 助勃药最好三个牌子 哪些助勃药品质最佳
0评论2025-10-04

- 国产他达拉非价格多少 国产他达拉非价格详解
0评论2025-10-04

- 红角惯爱药品功效 红角惯爱的三大作用
0评论2025-10-04

- 为什么禁止卖莓茶 揭秘莓茶的四大害处
0评论2025-10-03

- 药店不起眼的药瘦肚子 瘦肚子三个小妙招
0评论2025-10-03

- 蒲菊参芪五味化栀片功效与作用 蒲菊参芪五味化栀片的四大功效
0评论2025-10-03
药店让你瘦到怕的东西 瘦身最有效三个习惯
身体太过肥胖,除了会影响到心情以外,其实也有可能会增加各类健康问题的发生,所以还是要注重肥胖问题的处理,药店有不少能够让体重得到降低的物品,那么药店能够让人瘦到怕的东西是什么?瘦身最有效三个习惯又是哪些?下面带大家详细了解。药店让你瘦到怕的东西1、轻身消胖丸轻身消胖丸为中成药,是以麻黄、黄芪、荷叶、泽泻以及白术类中药材成分组合而成的,其中的原料能各司其职又可以互相辅助,共同作用之下是能够实现益气、
0评论2025-10-0324

- 国产口碑最好的他达拉非 哪些国产他达拉非片好
0评论2025-10-03

- 红角惯爱是干嘛用的 红角惯爱有什么作用
0评论2025-10-03

- 西地那非最好三个牌子 哪些品牌的西地那非好
0评论2025-10-03

- 国产他达拉非有哪些品牌 国产最好的他达拉非牌子
0评论2025-10-02

- 红角惯爱功效与作用 红角惯爱的三大作用
0评论2025-10-02

- 西地那非片哪个牌子好用 介绍4个西地那非片品牌
0评论2025-10-02

- 头晕必吃的六大水果 调理头晕的两大食疗方
0评论2025-10-01